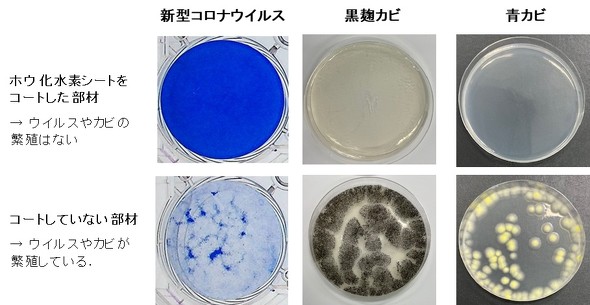

ホウ化水素シートの抗菌や抗ウイルス機能を確認 コロナにも有効:研究開発の最前線
筑波大学は、ホウ素と水素の組成比が1:1のホウ化水素シートが、抗菌や抗ウイルス、抗カビ機能を発揮することを確認した。ホウ化水素シートは、簡便な溶液プロセスにより大量合成が可能なナノシート状の物質だ。
筑波大学は2025年5月9日、ホウ素と水素の組成比が1:1のホウ化水素シートが、抗菌や抗ウイルス、抗カビ機能を発揮することを確認したと発表した。ホウ化水素シートは簡便な溶液プロセスにより大量合成が可能で、水素の貯蔵や輸送、触媒などへの応用が注目されるナノシート状の物質だ。
同大学と東京科学大学、高知工科大学、神奈川県立産業技術総合研究所の共同研究グループは、2.0mgのホウ化水素シートをガラス基材にコーティングした膜部材を作製。コートの膜厚は約2μmで、可視光領域の透過率はほぼ透明の80%以上を示した。
このコート部材に黄色ブドウ球菌と大腸菌をそれぞれ付着させて、一定時間経過後の生菌数を計測したところ、10分以内で検出限界値以下まで減少することが分かった。新型コロナウイルス、インフルエンザウイルス、ネコカリシウイルスを用いた同様の実験でも、感染力のあるウイルスの数であるウイルス感染価が、10分以内に検出限界値を下回り、抗菌、抗ウイルス機能を有することが明らかとなった。
また、黒麹カビや青カビを付着させた場合は、24時間後に生存カビ胞子数が検出限界値以下となる。これらの実験結果から、ホウ化水素シートが菌やウイルス、カビのいずれに対しても抑制する効果を発揮することが示唆された。
赤外分光法やアルカリホスファターゼを用いた酵素活性試験の解析により、ホウ化水素シートのタンパク質を変性させる特性により、菌やウイルスが不活化したと考えられる。
細胞毒性の検査では、ホウ化水素シートが動物細胞に及ぼす強い毒性は無いとされており、感染リスクを低減できる部材や繊維類などへの透明コーティング材としての活用が見込まれる。研究グループは今後、バインダーなどと複合化したコーティング剤の開発に取り組む考えだ。
関連記事
 常温常圧下で多元素酸化物触媒の合成に成功、製造コスト削減に貢献
常温常圧下で多元素酸化物触媒の合成に成功、製造コスト削減に貢献
高知工科大学と筑波大学は、常温常圧下で容易に多元素酸化物触媒を化学合成する手法を開発した。従来と比べて製造コストを大きく削減し、工業化に向けた大量生産が可能となる。 CNT繊維の強度低下の原因を解明、電子線の照射により高強度化
CNT繊維の強度低下の原因を解明、電子線の照射により高強度化
筑波大学と高度情報科学技術研究機構は、紡糸したカーボンナノチューブ繊維の強度が低下する原因を解明した。静止摩擦と動摩擦を繰り返すスティックスリップ挙動が起こり、分子同士の滑り現象が発生する。 酵母由来の界面活性剤が耐性菌を防ぎつつバイオフィルムを効果的に除去
酵母由来の界面活性剤が耐性菌を防ぎつつバイオフィルムを効果的に除去
筑波大学は、生物由来の界面活性剤が細菌を死滅させることなくバイオフィルムを除去し、さらに石油化学系の界面活性剤と組み合わせることで、除去効果が100倍以上向上することを発見した。 東大と筑波大が共同構築した最新スパコン「Miyabi」がAI for Scienceを推進する
東大と筑波大が共同構築した最新スパコン「Miyabi」がAI for Scienceを推進する
急速に進化するAI技術との融合により変わりつつあるスーパーコンピュータの現在地を、大学などの公的機関を中心とした最先端のシステムから探る本連載。第3回は、東京大学と筑波大学が共同で構築した「Miyabi」を紹介する。 東大筑波大の最新スパコン「Miyabi」が本稼働、性能は研究用で富岳に次ぐ第2位
東大筑波大の最新スパコン「Miyabi」が本稼働、性能は研究用で富岳に次ぐ第2位
東京大学 情報基盤センターと筑波大学 計算科学研究センターの共同組織である最先端共同HPC基盤施設(JCAHPC)は、最新のスパコン「Miyabi」を報道陣に公開した。
関連リンク
Copyright © ITmedia, Inc. All Rights Reserved.
素材/化学の記事ランキング
- ガラスや有機の限界を超える! 次世代セラミック基板を初披露
- レゾナックが生成AI向け半導体封止材の特許維持、異議申し立てを論破
- 失敗データも資産に! 研究現場を変える無料のノートアプリ
- 生成AIブームを支える材料、JX金属が生産能力増強を決定
- 半導体やフォルダブルスマホに照準、日東電工が描く次世代の成長戦略
- 廃棄エアコンからレアアース磁石を回収、国内使用量の35%を賄う
- トクヤマが台湾で半導体用高純度IPAの第2プラント建設、生産能力は……
- 銅の地政学リスク、「普通に勝負していたら勝てない状況」
- 次世代半導体向けガラスコア基板の課題打破、TGV深穴加工に成功
- InP基板へ1200億円投資! AI需要急増を受け生産能力を最大10倍に
コーナーリンク